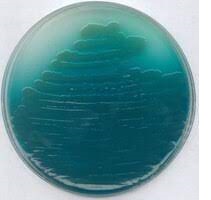
Pseudomonas Isolation Agar 500g

Description
General description
Pseudomonas Isolation Agar is used as a selective and differential medium for primary isolation and identification of Pseudomonas aeruginosa. It is a modified medium based on the formulation of Medium A by King et al. and developed to differentiate Pseudomonas aeruginosa from other Pseudomonas sp. based on pigment formation. Peptic digest of animal tissue provides nitrogenous compounds. Glycerol serves as carbohydrate source and promotes the phycocyanin (blue-green pigment) production. Magnesium is a cofactor for many metabolic reactions and together potassium sulphate stimulates phyocyanin production as well. Irgasan is an antibiotic and selective inhibits gram-positive and gram-negative bacteria other than Pseudomonas spp. Agar is the solidifying agent.
Application
Pseudomonas Isolation Agar is used as a selective and differential medium for primary isolation and identification of Pseudomonas from clinical and nonclinical specimens.
Properties
sterility
non-sterile
form
powder
shelf life
limited shelf life, expiry date on the label
composition
agar, 13.6 g/L
magnesium chloride, 1.4 g/L
peptic digest of animal tissue, 20 g/L
potassium sulfate, 10 g/L
triclosan (Irgasan), 0.025 g/L
packaging
pkg of 500 g
technique(s)
microbiological culture: suitable
final pH
7.0±0.2 (25 °C)
application(s)
agriculture
clinical testing
environmental
food and beverages
water monitoring
microbiology
storage temp.
2-25°C
suitability
selective for Pseudomonas spp.

Reviews
There are no reviews yet.